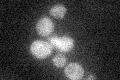
YMR096W
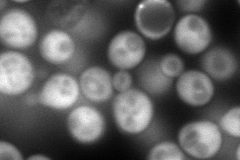
YMR096W
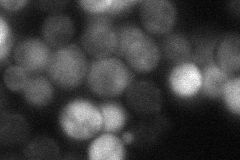
YMR096W
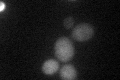
YMR096W
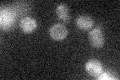
YMR096W

View description
Protein involved in vitamin B6 biosynthesis; member of a stationary phase-induced gene family; coregulated with SNO1; interacts with Sno1p and with Yhr198p, perhaps as a multiprotein complex containing other Snz and Sno proteins
Localization:
Intensity:
Fold change:
Significance:
-
C’ GFP library in SD
below threshold18.75 -
N' NOP1pr-GFP in SD
cytosol234.724 -
N' TEF2pr-mCherry in SD

cytosol296.808 -
N' NATIVEpr-GFP in SD
punctate20.2449 -
N' TEF2pr-VC and Cyto-VN in SD

#N/A0 -
C’ GFP library in SD+DTT
cytosol19.361.03No -
C’ GFP library in SD+H2O2
cytosol18.440.98No -
C’ GFP library in Starvation Media

cytosol160.85No -
C’ GFP library on the background of Pup2-DaMP

below threshold -
C’ GFP library on the background of CCT mutant

below threshold22.56021.20291No
